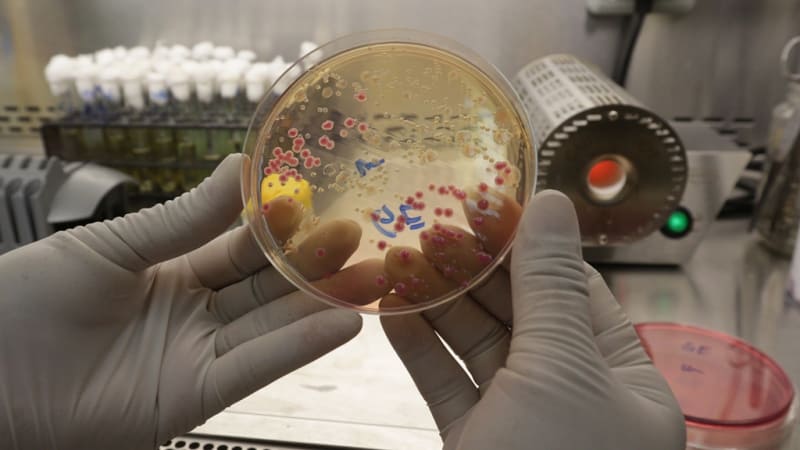

- Beranda
- Komunitas
- News
- Berita dan Politik
Presiden Jokowi: Kalau Mau Kaya Cari Racun Kalajengking
TS
soekirmandia
Presiden Jokowi: Kalau Mau Kaya Cari Racun Kalajengking
Presiden Jokowi:
Kalau Mau Kaya Cari Racun Kalajengking
SENIN, 30 APR 2018 13:32

Jokowi sebut racun kalajengking mahal.(Foto: Putri Sarah Arifira/kumparan)
JawaPos.com - Presiden Joko Widodo (Jokowi) menghadiri pembukaan Musyawaran Perencanaan Pembangunan Nasional (Musrenbangnas) 2019. Hampir seluruh kepala daerah hadir dalam acara tersebut.
Mengawali sambutan, mantan Wali Kota Solo ini bertanya kepada kepala daerah yang hadir. "Sekarang saya mau bertanya, apa komoditas paling mahal di dunia? Pasti banyak yang menjawab emas. Bukan emas," ujarnya di Hotel Grand Sahid, Jakarta, Senin (30/4).
Presiden juga mengatakan, saat ini emas bukan lagi komoditi termahal dunia. Berdasarkan informasi yang diketahuinya, ternyata racun kalajengking mampu mengalahkan harga emas.
Berbagai sumber menyebutkan bahwa harga racun kalajengking bisa mencapai USD 10.5 juta atau sekitar Rp 146 miliar (kurs Rp 13.900). Selain bermanfaat untuk medis, racun tersebut juga sangat mematikan.
"Ada fakta yang menarik yang saya dapat dari informasi yg saya baca. Komoditas paling mahal sekarang itu racun dari Kalajengking. Harganya USD 10,5 juta per liter artinya sekitar Rp 140 miliar," paparnya.
Mantan Gubernur DKI Jakarta ini pun lantas melontarkan candaan kepada kepala daerah yang hadir. "Pak bupati dan walikota kalo mau kaya cari racun kalajengking," kata Presiden Jokowi disambut tawa.
Selain itu, komoditas mahal lainnya yakni kalifornium yang merupakan logam radioaktif dan biasa digunakan untuk eksplorasi minyak dan gas. Dia menegaskan bahwa sekarang sudah semakin banyak komoditas yang harganya terus menjadi mahal.
"Ada lagi komoditas paling mahal. Zat kimia untuk eksplorasi minyak dan gas. USD 27 juta per gram Rp 375 miliar per gram," tutupnya.
Darah Komodo Bisa Jadi Antibiotik dan Obat Masa Depan

Rangga, Komodo di Taman Safari Bogor. (Foto: Niken Nurani/kumparan)
[ltr]Infeksi akibat gigitan komodo dapat membunuh korbannya dalam waktu beberapa hari saja, kurang dari seminggu. Sebab, di dalam air liur komodo terkandung bakteri dan racun.[/ltr]
[ltr]Namun begitu, gigitan komodo tidak mematikan bagi komodo lain. Dengan kata lain, tak masalah jika mereka bertengkar dan saling gigit.[/ltr]
[ltr]Para peneliti melihat kadal purbakala itu tampak tidak terpengaruh oleh bakteri dan racun yang mematikan dari sesamanya.[/ltr]
[ltr]Baru-baru ini para peneliti menyatakan, peptida yang memperkuat sistem kekebalan komodo dapat dimanfaatkan oleh manusia sebagai antibiotik untuk melawan bakteri-bakteri yang membahayakan kesehatan tubuh. Peptida adalah molekul yang terbentuk dari dua atau lebih asam amino --komponen utama penyusun protein yang menjadi bahan dasar pembentuk sel, otot, dan sistem kekebalan tubuh.[/ltr]
[ltr]Para peneliti di George Mason University telah mempelajari darah komodo guna mengidentifikasi molekul yang menyebabkan kawanan hewan itu memiliki kekebalan alami yang begitu kuat. [/ltr]
[ltr](Baca juga: Bakteri dan Racun Berbahaya di Air Liur Komodo)[/ltr]
[ltr]"Kekebalan bawaan adalah garis pertahanan pertama melawan infeksi dan sangat adaptif terhadap tantangan lingkungan," kata Barney Bishop PhD, sang peneliti utama, sebagaimana dilansir Healthline, Selasa (25/4). Selain Bishop dan peneliti-peneliti lainnya yang berasal dari George Mason University, tim penelitian itu juga beranggotakan Monique van Hoek PhD, profesor dari School of Systems Biology[/ltr]
Para komodo itu diketahui makan daging bangkai dan selama periode waktu menyimpan kadar bakteri yang tinggi di mulut mereka, termasuk jaringan bakteri yang berpotensi sebagai patogen. (Tapi) mereka nampaknya tidak menderita efek-efek negatif dari bakteri-bakteri tersebut.
- Barney Bishop
Dalam prosesnya, para peneliti telah memilah ratusan peptida yang ada di dalam darah komodo. Mereka menemukan lebih dari 200 peptida, dan yang menarik dari peptida itu ialah sifat-sifatnya yang bisa menjadi antimikroba.
[ltr]Tim peneliti kemudian menyusun kembali asam amino peptida untuk menciptakan versi sintetis dari peptida alami komodo yang lebih kuat dan lebih stabil. Mereka menyebut susunan peptida buatan itu sebagai DRGN-1.[/ltr]
Monique van Hoek menjelaskan, "DRGN-1 bekerja dalam tiga cara. Pertama, antibakteri terhadap bakteri yang menginfeksi luka. Kedua, memiliki efek antibiofilm terhadap biofilm yang dihasilkan oleh bakteri tersebut --kedua hal ini membantu menghilangkan bakteri dari luka. Dan ketiga, peptida DRGN-1 membantu luka untuk menutup lebih cepat dan dengan demikian mendorong penyembuhan luka.”
[ltr]Awalnya, penelitian ini akan digunakan untuk membantu tentara dalam proses penyembuhan secara cepat, melindunginya dari senjata-senjata biologis. Namun para peneliti memperhitungkan, ke depannya temuan ini juga bisa bermanfaat bagi masyarakat umum.[/ltr]
Kami berpikir bahwa peptida seperti DRGN-1 dapat membantu mengobati luka yang terinfeksi di masa depan, termasuk luka di medan perang, borok kaki akibat diabetes, luka bakar, dan akhirnya dapat membantu banyak orang dengan jenis-jenis infeksi kulit seperti ini.
- Monique van Hoek
Kegiatan penelitian tersebut masih berlanjut hingga kini. Untuk kesinambungan penlitian, dana hibah sebesar 7,5 juta dolar AS dari Defense Threat Reduction Agency (DTRA) digelontorkan. Penelitian itu diharapkan dapat benar-benar menemukan senyawa baru yang mampu mengalahkan bakteri-bakteri yang resisten terhadap antibiotik-antibiotik yang ada saat ini.
[ltr]Dewasa ini telah banyak ditemukan berbagai penyakit yang disebabkan oleh bakteri-bakteri yang resisten atau tahan terhadap antibiotik. Jenis bakteri yang kebal terhadap obat-obatan antibiotik itu disebut sebagai superbugs. (Baca juga: Mengenal Superbugs, Bakteri Berbahaya yang Menyerang Nadia Vega)[/ltr]
Teknisi laboratorium menunjukan sample bakteri. (Foto: Aditia Noviansyah/kumparan)
[ltr]Menurut satu penelitian yang dipublikasikan di PLOS Medicine dan diulas di Review on Antrimicrobial Resistance, superbugs diprediksi akan membunuh 10 juta orang dalam setahun pada 2050 bila dunia tak bertindak dari sekarang. Artinya, satu orang akan mati setiap tiga detik pada tahun 2050 akibat bakteri tersebut.[/ltr]
[ltr]Meski peptida dalam darah komodo belum tentu terbukti bisa menjadi antibiotik, tapi petunjuk-petunjuk baik yang mengarah ke sana patut menjadi harapan banyak orang.[/ltr]
[ltr]David Weiss PhD, Direktur Emory Antibiotic Resistance Center, mengatakan penemuan dari penelitian darah komodo itu mengagumkan.[/ltr]
[ltr]"Mengingat keadaan mengerikan dalam melawan bakteri yang tahan terhadap antibiotik, semua petunjuk harus diikuti," ucap Weiss.[/ltr]
-----------------------------------

Itu racun kalajengking itu, kalo langsung diminum apa bisa sembuh penyakitnya, ya pak?

0
2.4K
17
Komentar yang asik ya
Urutan
Terbaru
Terlama
Komentar yang asik ya
Komunitas Pilihan